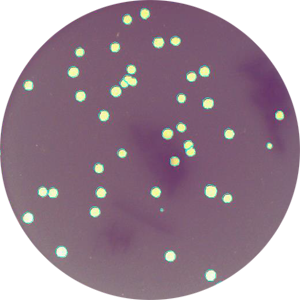
Application Various colonies in 6 well plates and on 35 mm - 100 mm petridishes

Colony counting
Application
Various colonies in 6 well plates and on 35 mm - 100 mm petridishes

EAZYREADER® 7000
World's first 100 % scalable Elispot/Plaque Reader that may be upgraded on-site to a Single Cell/PBMC counter.

BIOREADER® 7000 -F-z-i
Versatile, Inverted high resolution Zoom Fluoro/VIS reader, micro + macro mode with innovative power LED fluoro excitation

BIOREADER® 7000 -V
For non-fluoro applications in 384 well to 6 well plates and Petri dishes.
Application
Various media/strain combinations on petridishes


EAZYREADER® 7000
World's first 100 % scalable Elispot/Plaque Reader that may be upgraded on-site to a Single Cell/PBMC counter.

BIOREADER® 7000 -F-z-i
Versatile, Inverted high resolution Zoom Fluoro/VIS reader, micro + macro mode with innovative power LED fluoro excitation

BIOREADER® 7000 -V
For non-fluoro applications in 384 well to 6 well plates and Petri dishes.




